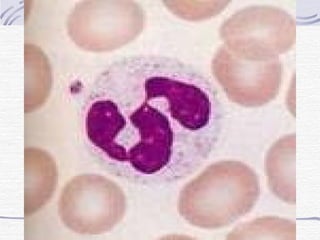
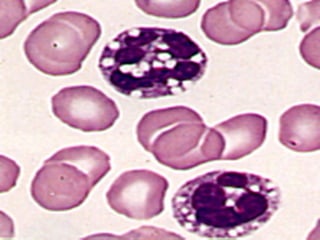
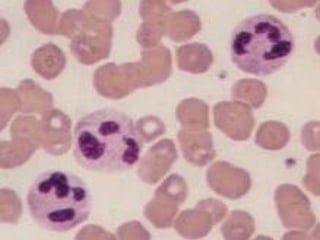
Neutrófilos
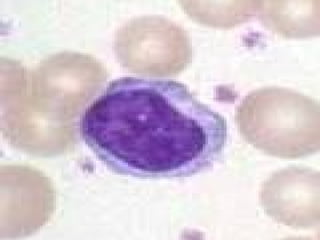

O documento descreve as principais características morfológicas e funções dos leucócitos. Neutrófilos fagocitam corpos estranhos e liberam enzimas para combater infecções. Linfócitos T e B atuam no sistema imunológico celular e humoral, respectivamente. Monócitos fagocitam patógenos e apresentam antígenos.